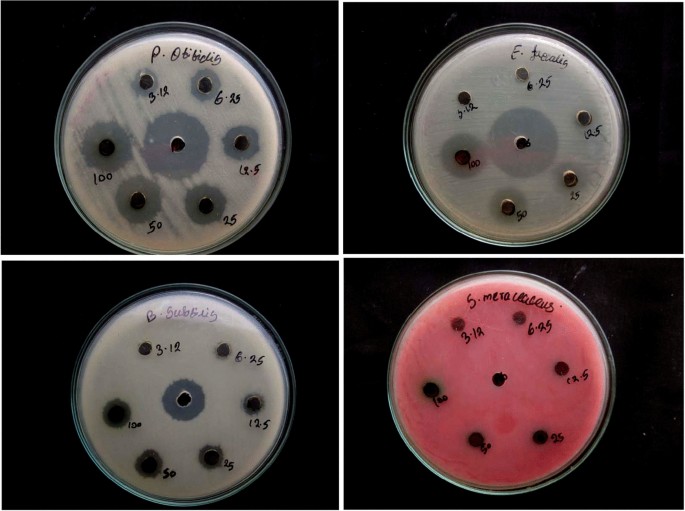

Image
Figure Caption
Fig. 7 Antibacterial activity of C. serrulata ethyl acetate extract CS- ZnO NPs against human pathogens
Acknowledgments
This image is the copyrighted work of the attributed author or publisher, and
ZFIN has permission only to display this image to its users.
Additional permissions should be obtained from the applicable author or publisher of the image.
Full text @ 3 Biotech